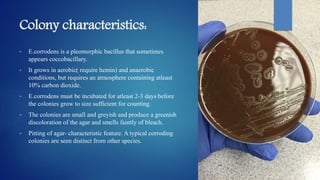
Colony characteristics:
• E.corrodens is a pleomorphic bacillus that sometimes
appears coccobacillary.
• It grows in aerobic( require hemin) and anaerobic
conditions, but requires an atmosphere containing atleast
10% carbon dioxide.
• E.corrodens must be incubated for atleast 2-3 days before
the colonies grow to size sufficient for counting.
• The colonies are small and greyish and produce a greenish
discoloration of the agar and smells faintly of bleach.
• Pitting of agar- characteristic feature. A typical corroding
colonies are seen distinct from other species.

The document discusses periodontal pathogens and their role in periodontitis, a polymicrobial disease involving complex interactions between oral microorganisms and the host immune response. It explains the criteria for identifying these pathogens, particularly focusing on key species such as Aggregatibacter actinomycetemcomitans and Porphyromonas gingivalis, which fulfill the established criteria for periodontal pathogens due to their virulence factors and association with disease. Additionally, it highlights the challenges in defining these pathogens due to the complexity of the subgingival microbiota and the mixed infections that can occur.